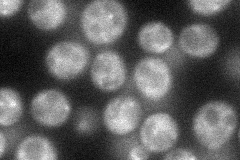
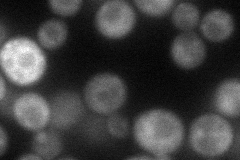
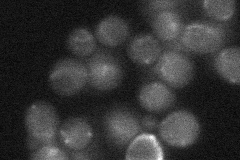
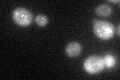
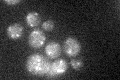

View description
Ubiquitin isopeptidase, required for recycling ubiquitin from proteasome-bound ubiquitinated intermediates, acts at the late endosome/prevacuolar compartment to recover ubiquitin from ubiquitinated membrane proteins en route to the vacuole
Localization:
Intensity:
Fold change:
Significance:
-
C’ GFP library in SD

punctate23.38 -
N' NOP1pr-GFP in SD
punctate41.3928 -
N' TEF2pr-mCherry in SD
cytosol,punctate48.7455 -
N' NATIVEpr-GFP in SD
cytosol,punctate21.8782 -
N' TEF2pr-VC and Cyto-VN in SD

cytosol35.6815 -
C’ GFP library in SD+DTT
punctate23.551No -
C’ GFP library in SD+H2O2

punctate22.630.96No -
C’ GFP library in Starvation Media
punctate22.790.97No -
C’ GFP library on the background of Pup2-DaMP

punctate -
C’ GFP library on the background of CCT mutant

punctateN/AN/ANo
